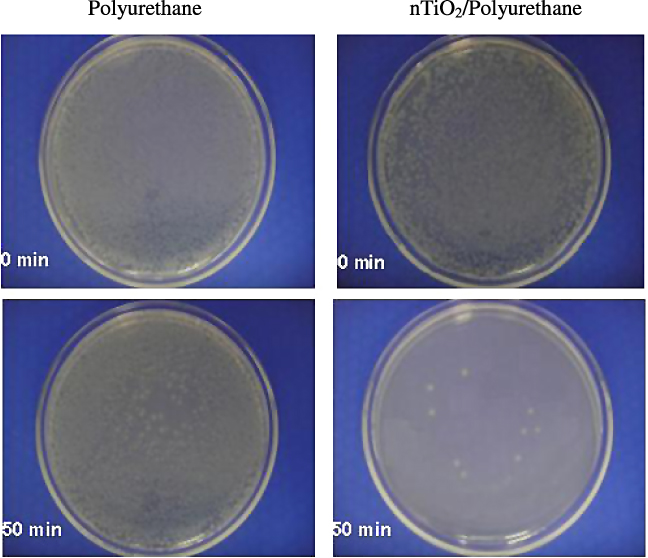
Figure 8.

Abstract
Grafting from polymerization was used to synthesize nano-titania/polyurethane (nTiO2/polyurethane) composite coatings, where nTiO2 was chemically attached to the backbone of the polyurethane polymer matrix with a bifunctional monomer, 2,2-bis(hydroxymethyl) propionic acid (DMPA). This bifunctional monomer can coordinate to nTiO2 through an available –COOH group, with two available hydroxyl groups that can react with diisocyanate terminated pre-polyurethane through step-growth polymerization. The coordination reaction was monitored by FTIR and TGA, with the coordination reaction found to follow first order kinetics. After step-growth polymerization, the polyurethane nanocomposites were found to be stable on standing with excellent distribution of Ti in the polymer matrix without any significant agglomeration compared to simple physical mixtures of nTiO2 in the polyurethane coatings. The functionalized nTiO2–polyurethane composite coatings showed excellent antibacterial activity against gram-negative bacteria Escherichia coli; 99% of E. coli were killed within less than one hour under solar irradiation. Self-cleaning was also demonstrated using stearic acid as a model for 'dirt'.
Export citation and abstract BibTeX RIS
1. Introduction
Self-cleaning and antibacterial surfaces using nanostructured titania (nTiO2) have been of significant recent academic and industrial interest [1–7]. Research into TiO2 as a photocatalyst semiconductor originally began in the early 1970s with the pioneering work of Honda and Fujishima who investigated the splitting of water into oxygen and hydrogen using TiO2 irradiated by UV light [8]. Currently, TiO2 photocatalysis is actively used in the field of photodegradation of organic compounds, specifically in environmental decontamination of air [9] and water [10]. Although most photocatalytic self-cleaning coating research has focused on self-cleaning glass [11, 12], self-cleaning polymers for paints and coatings are of significant potential industrial and scientific importance. However, little work has been performed on the chemistry for the integration of nano-titania (nTiO2) into polymers for self-cleaning coatings, in which the nanoparticles are chemically linked to the polymer chains. As dirt and bacteria accumulate on almost every surface, nanocomposites that provide antibacterial and self-cleaning behavior would be of significant interest.
Inorganic/organic hybrids are emerging materials for polymer coatings due to their extraordinary and unique combination of properties originating from the synergism between the inorganic nanoparticles and the polymer. Addition of a relatively small amount of the nanoparticles (e.g., less than 10 wt%) dramatically changes the properties of the resulting polymer nanocomposite. As examples, nTiO2 has been used as a radiopacifier in dental composites and bone cements [13], as a dye in a conjugated polymer for photoelectrochemical [14] or photoconductive [15] agents, and as a photocatalyst in photodegradable TiO2–polystyrene nanocomposite films [16]. Due to their extremely large surface-area/particle-size ratio, nanoparticles have a thermodynamic tendency to aggregate into clusters, reducing the resultant properties of the nanocomposite materials [17]. Although several nTiO2/polyurethane coatings prepared by physical blending with antibacterial capabilities have been reported, there still remain barriers in antibacterial and self-cleaning applications due to agglomeration and uneven distribution of nTiO2, which affect the final properties of the products [18]. Moreover, significant nTiO2 leaching occurs during the light irradiation from the surface of the coatings, leading to drastic reduction in photocatalytic activity [19]. Therefore, it is desirable to develop functionalized nTiO2/polyurethane nanocomposite coatings, where nTiO2 is chemically attached to the backbone of the polyurethane polymer matrix.
Many efforts have been made in order to increase the nanoparticle dispersion and to enhance the filler–matrix interactions [20]. Increasing the dispersion of TiO2 nanoparticles into a PVC polymer matrix was shown to increase the photocatalytic degradation significantly [21, 22]. One approach is to break down the agglomerated nanoparticles using a mechanical method such as ultrasonic irradiation, which has been explored for dispersion of SiO2, TiO2 and Al2O3 nanoparticles during the synthesis of inorganic/polymer nanocomposite materials [23]. However, this approach is restricted due to the limited interaction between the inorganic fillers and the organic matrix, compared with the very strong interaction between individual nanoparticles. An improved approach termed 'grafting from' polymerization involves growing polymer chains from a nanosurface providing potentially higher graft densities and better control of the molecular weight and polydispersity of the polymer chains [24].
In this study, polymer nanocomposite films were prepared using the 'grafting from' strategy with nTiO2 and polyurethane (PU), which is a well known polymer used in outdoor applications with excellent mechanical and weathering properties [25]. Coatings made from polyurethanes commonly contain TiO2 (rutile) as a UV blocking agent and are widely used in various industries due to their durability and overall good balance of mechanical properties [26, 27]. We have previously shown that functionalization can occur by coordinating a carboxylic acid group with nTiO2 [13, 28]. Here nTiO2 was dispersed homogeneously with bifunctional agent without any significant agglomeration. Several physico-chemical characterization techniques were used to verify the coordination reaction between DMPA and nTiO2 including SEM, TGA, ATR-FTIR and EDX. The antibacterial activities of the nanocomposite coatings were evaluated by the photo-killing of gram-negative bacteria E. coli under solar irradiation (AM 1.5).
2. Experimental details
2.1. Chemicals
All chemicals used were obtained from Sigma-Aldrich Canada (Mississauga, ON). 4,4-methylene bis(p-phenyl isocyanate) (MDI) was purified using hot filtration of the melt with Whatman 50 filter papers at a temperature of 65 °C under vacuum. Poly(tetrahydrofuran) (PTHF) with an average molecular weight of 1000 Daltons was heated at 90 °C under vacuum to remove all moisture. 2,2-bis(hydroxymethyl)propionic acid (DMPA) was washed and filtered under vacuum with distilled reagent plus methanol, and recrystallized under vacuum at 70 °C. Titanium (IV) oxide nanopowder (nTiO2) with an average particle size of 25 nm at 99.9% purity, comprised of 50% anatase and 50% rutile crystal forms, toluene anhydrous, 99.8%, dimethylformamide (DMF) ACS reagent, ≥99.8%, and tetrahydrofuran (THF) anhydrous, ≥99.9%, inhibitor-free were all used as prepared by Sigma-Aldrich. Laboratory grade water (LGW, 18 MΩ) was prepared by an in-house Millipore purification system (Billerica, MA). Escherichia coli (DH 5α) were obtained from the laboratory stock of the Chemical and Biochemical Engineering Department of the University of Western Ontario. Other materials for bacteria cultivation, such as agar and Luria broth (LB), were also obtained from Sigma-Aldrich (Mississauga, ON).
2.2. Synthesis of nTiO2/polyurethane composite coatings. Monomer (DMPA–nTiO2) functionalization
To synthesize the functionalized monomer of DMPA–nTiO2, the titania nanospheres (nTiO2) and DMPA were dispersed in 2-propanol with the aid of ultrasonic agitation. The mixture of nTiO2 and DMPA in 2-propanol was then reacted at 80 °C under constant magnetic stirring and in an inert atmosphere (argon gas) for 12 h to synthesize the functionalized monomer DMPA–nTiO2 as shown in scheme 1. The ratio of DMPA to nTiO2 was varied to obtain DMPA–nTiO2 with different mol% nTiO2. The DMPA was originally a white powder which turned to a yellowish crystalline powder after the reaction with nTiO2 (figure S1 in supporting information available at stacks.iop.org/Nano/23/425606/mmedia). The DMPA–nTiO2 particles were removed from the mixture by centrifugation at 8000 rpm after washing by methanol to remove excess DMPA from the functionalized DMPA–nTiO2.
Scheme 1. The coordination reaction between the surface of the DMPA and the nTiO2.
Download figure:
Standard imagenTiO2/polyurethane composite synthesis. The segmented nTiO2/polyurethane composite coatings were synthesized by a novel two step process as shown in scheme 2 using 4,4-methylene bis(p-phenyl isocyanate) (MDI) and 2,2-bis(hydroxymethyl)propionic acid (DMPA)–nTiO2 for the hard segment and PTHF for the soft segment. In the first step (prepolymerization), MDI was reacted with PTHF at a molar ratio of 2:1 under argon gas and solvent (DMF/toluene) at 85 °C for 2 h and was constantly mixed by magnetic stirring. Due to the long organic chain length of PTHF and its insolubility in most oxygenated solvents, a mixture of DMF/toluene at 1:1 volume ratio was used as the reaction medium. Dibutyltin dilaurate (DBTDL) was used as the catalyst at a wt% of 0.001. The prepolymer was then polymerized at 1:1 molar ratio with chain extender, DMPA–nTiO2, for 4 h at 80 °C as shown in scheme 2. The nTiO2/polyurethane composite coatings with a wet thickness of 150 ± 5 m were prepared on degreased glass substrates (50 mm × 50 mm × 3 mm) using a spin coater (model: WS-400-6NPP-LITE, Laurell). The film was then dried at 80 °C for 12 h under vacuum and used for different characterizations and testing for antimicrobial and self-cleaning properties.
Scheme 2. Functionalized DMPA–nTiO2/polyurethane composite coating synthesis using the monomer approach.
Download figure:
Standard image2.3. Characterization of the nTiO2/polyurethane composite coatings
The surface morphology of the functionalized nTiO2/polyurethane composite coatings was studied by scanning electron microscopy (SEM) micrographs (model: LEO 1530). The bulk composition was analyzed using energy-dispersive x-ray spectroscopy (EDX) attached to a LEO 1530 scanning electron microscope (SEM) to measure the dispersion and compositional analysis of nTiO2 in the polymer matrix. In situ FTIR was used to identify the coordination of carboxylate groups to nTiO2 for the reaction conditions of a temperature of 80 °C, a pressure of 1 atm and a rotational speed of 300 rpm using a Mettler Toledo® ReactIR 4000 spectrometer in a 100 ml reactor where the spectrometer provided spectra in the range of 400–4000 cm−1 and was operated using 32 scans at 4 cm−1 resolution for each reaction time sequence of 1 h intervals. The functional chemical groups in the synthesized nTiO2–polyurethane composites were identified by attenuated total reflection-Fourier transform infrared (ATR-FTIR) spectroscopy (Nicolet 6700). The ATR-FTIR was equipped with a single reflection ATR accessory with a ZnSe crystal. The spectra were recorded within the range of 500–4000 cm−1 with a resolution of 4 cm−1 over 32 scans. Thermogravimetric analysis (TGA) was performed to determine the extent of coordination of the TiO2 to the DMPA from the weight loss using a TA Q500 TGA at a heating rate of 10 °C min−1 under an inert (nitrogen) atmosphere.
2.4. Antimicrobial test
The antimicrobial activity of the nTiO2/polyurethane composite coatings was determined using gram-negative bacterium E. coli as the test culture. E. coli cells were precultured on the LB–agar medium overnight in an incubator at 38 °C and 200 rpm, and then washed by centrifugation with phosphate buffer saline (PBS) at 4000 rpm. The treated cells were then re-suspended and diluted to ∼1 × 105 colony forming units (CFU)/ml with sterilized water to measure the optical density with a UV–vis spectrophotometer operated at 600 nm. The cell suspensions were kept at 4 °C to minimize potential bacterial growth. Thereafter, the diluted cell suspension (1500 μl) was pipetted onto nTiO2/polyurethane coated glass plates, which were placed in an airtight illumination chamber to prevent drying (figure S2 in supporting information available at stacks.iop.org/Nano/23/425606/mmedia). The chamber was then illuminated using a solar simulator (model: SS1KW, Sciencetech, ON, Canada) with a 1000 W xenon arc lamp and an air mass filter (AM filter) AM1.5G, which produces identical simulated 1 SUN irradiance of 100 mW cm−2 at full power that matches the global solar spectrum (class A standards as per JIS-C-8912 and the ASTM) at sea level and a zenith angle of 37°. The illumination intensity was measured at the top surface of the experimental solution by a broadband thermopile detector (model: UP19K-15W, Sciencetech, ON, Canada), which allows measurement of the radiation emitted by a light source having a wavelength between 190 nm and 11 μm (UV–vis–IR) and the power density on a surface (mW cm−2). After being illuminated for various investigated periods of time, 200 μl of the cell suspension was collected and pipetted onto LB–agar medium in a Petri dish, and then incubated for 24 h at 38 °C to determine the number of viable cells in terms of colony forming units (CFUs) using ImageJ software. The antibacterial properties of the coatings were calculated based on the ratio of surviving bacteria on the sample to the initial number of bacteria on a control sample as follows:

where N0 and N are the number of CFUs before and after illumination respectively. In the control test, inactivation of E. coli was not found in the absence of solar illumination. All the experiments were conducted in triplicate with average error within 5%, and the results were reported with error bars.
2.5. Self-cleaning test
The self-cleaning properties of the nTiO2/polyurethane composite films were studied using ATR-FTIR spectra analysis. Stearic acid was used as the model dirt compound and the FTIR spectra of the stearic acid film in contact with the nTiO2/polyurethane composite coating were recorded before and after solar irradiation using an ATR-FTIR spectroscope (Nicolet 6700 FTIR), which was connected to a computer, supported by Thermo Scientific OmnicTM software. The spectra were collected in the range of 500–4000 cm−1 with 32 scans for each sample to measure and identify the variations of the functional groups and characteristic peaks.
3. Results and discussion
3.1. Monomer functionalization
3.1.1. FTIR analysis.
The bifunctional agent, 2,2-bis(hydroxylmethyl) propionic acid (DMPA), was reacted with nano-titanium dioxide (nTiO2) to form a functionalized monomer, termed DMPA–nTiO2, as shown in scheme 1. This coordination reaction was examined using in situ FTIR spectroscopy, as shown in figure 1, as FTIR is an established protocol for examining metal carboxylate chemistry [29]. The characteristic peak at 1710 cm−1 for the carbonyl group (C=O) stretch and the two C–O peaks at 1050 and 1225 cm−1 in DMPA all decreased over a reaction time from 0 to 12 h. This indicates that the functionalization reaction of DMPA with nTiO2 removed the C=O and C–O groups, replacing them with coordination bonding to nTiO2. The small peak changes at 1410 and 1470 cm−1 indicate changes in the titanium coordination peaks over the reaction time. Functionalization of DMPA with n-TiO2 was further determined by calculating the concentration profile of DMPA using the in situ FTIR data. Assuming the coordination reaction as a first order reaction, the rate equation can be described as follows:

Figure 1. In situ FTIR results for the functionalization of DMPA with nTiO2.
Download figure:
Standard imageFigure 2 plots the natural logarithm of the ratio of the initial DMPA concentration ([M0]) to the actual DMPA concentration ([M]) over time. The two peaks at 1050 and 1710 cm−1 differ slightly, which can be associated with the FTIR system error, in which the data from one peak are constantly higher than the data from the second peak. From figure 2, it is found that the overall reaction takes approximately 10 h for completion, including a lag time of approximately 5 h. This lag time is rationalized by DMPA crystal restructuring in solvent to lose internal hydrogen bonding, such that the functionalization reaction to nTiO2 can take place.
Figure 2. Kinetic data for DMPA and nTiO2 functionalization.
Download figure:
Standard imageThe functionalized DMPA–nTiO2 monomer was further characterized using offline ATR-FTIR spectroscopy comparing with the characterization peaks for nTiO2 and DMPA as shown in figure 3. The DMPA–nTiO2 trace shows that the peaks at 1710 cm−1 (C=O peaks), 1250 and 1050 cm−1 (both C–O peaks) decrease, indicating that a reaction has taken place. The C=O bonds and C–O peaks associated with the carboxylic acid group of DMPA are replaced with a conjugated carboxylate group of DMPA–nTiO2. The FTIR results for DMPA–nTiO2 show three Ti functionalization peaks between 1350 and 1550 cm−1 which are similar to previously reported data and these peaks are slightly shifted as the acetate coordination to TiO2 changes in different chemical environments, causing shifting of the acetate peaks [13, 30]. The carboxylate coordination to the Ti surface can have three possible chemical structures: (a) chelating bidentate, (b) bridging bidentate and (c) monodentate (figure S4 in supporting information available at stacks.iop.org/Nano/23/425606/mmedia) [31]. The binding mode between the carboxylic acid and the nTiO2 was determined using infrared spectra by calculating the separation (Δνa–s) between the asymmetric (νas) and symmetric (νs) stretching bands of C–O. In our case Δνa–s was obtained as 93 cm−1, which implies that a bidentate chelating type coordination bonding exists between the DMPA and the nTiO2. Therefore the coordination reaction between the DMPA and the surface of the nTiO2 is consistent with that shown in scheme 1.
Figure 3. FTIR spectra of DMPA, nTiO2 and functionalized DMPA–nTiO2.
Download figure:
Standard image3.1.2. Thermogravimetric analysis.
The DMPA–nTiO2 monomer was characterized by thermogravimetric analysis (TGA) to obtain quantitative information about the coordination of nTiO2 to DMPA. According to figure 4, the decomposition of alcohols and carboxylic acids begins at approximately 172 °C [32, 33] and the decomposition of the remaining oxidized carbon chain starts at approximately 293 °C. A third step of thermal decomposition that begins at approximately 350–370 °C is due to the coordination reaction between the nTiO2 and the DMPA. This third peak represents the functionalized carboxylate groups chemically bonded to the nTiO2. After 450 °C, there is no apparent weight loss, indicating that all DMPA has been removed. Therefore, there was ∼40% weight loss due to the decomposition of the DMPA. The graft density of the DMPA on the nTiO2 surface was calculated to obtain the molar number of DMPA molecules anchored onto one TiO2 nanoparticle from the BET and TGA results [24]. As per our calculation (Cal. S1 in supporting information available at stacks.iop.org/Nano/23/425606/mmedia), ∼40% of the DMPA in the DMPA–nTiO2 composite, i.e. 29.8 mmol g−1 of DMPA, is equivalent to 18 grafting agents nm−2 (surface area of nTiO2), while the bulk density of the DMPA–nTiO2 was calculated as 2.89 g cm−3. From all the analysis results obtained using in situ FTIR, ATR-FTIR and TGA, it is evident that the DMPA monomer has been successfully functionalized with nTiO2.
Figure 4. TGA graph of functionalized DMPA–nTiO2. Inset: DTG curve for functionalized DMPA–nTiO2.
Download figure:
Standard image3.2. Functionalized nTiO2/polyurethane composite coatings
3.2.1. ATR-FTIR analysis.
As illustrated in scheme 2, nTiO2/PU nanocomposites were synthesized using the DMPA–nTiO2 monomer via the 'grafting from' polymerization technique. The FTIR spectra for the nTiO2/polyurethane nanocomposite coatings showed all anticipated peaks, as shown in figure 5, i.e., the N–H peak at 3350 cm−1, the carbonyl peak at 1710 cm−1 from the characteristic urethane linkage, and the lack of an isocyanate peak at 2265 cm−1 [34]. The functionalization peaks between DMPA and nTiO2 as observed in figure 3 are not distinguishable in the FTIR spectra, because the absorption level for Ti–O–C coordination is almost negligible compared to that of the polyurethane peaks. However, the nTiO2 incorporation into the nTiO2/polyurethane nanocomposite was confirmed by TGA (not shown). The FTIR spectra for the prepolymer were not measured because the –NCO end groups react to form an aldehyde end group once exposed to humid air.
Figure 5. FTIR spectra for optimized nTiO2–polyurethane composite coatings.
Download figure:
Standard image3.2.2. Compositional homogeneity analysis.
Figure 6 indicates that there is no settling of nTiO2 from the functionalized nTiO2/polyurethane emulsion prepared by our novel 'grafting from' method even after 12 weeks. This is due to the chemical bonding between polyurethane chains and nTiO2, which was achieved by coordination of DMPA. The direct attachment of nTiO2 to the polymer chains allows excellent dispersion of the nTiO2 throughout the polyurethane matrix. For comparison, a conventional nTiO2/polyurethane mixture was prepared by dispersing nTiO2 in polyurethane using ultrasonication, and was well dispersed initially, but after standing for three days, most of the nTiO2 was precipitated and settled to the bottom (figure 6(a)).
Figure 6. Images of (a) nTiO2/polyurethane emulsion prepared by a conventional physical mixture method after standing for three days and (b) functionalized nTiO2–polyurethane composite coatings prepared by our novel 'grafting from' method after standing for 12 weeks.
Download figure:
Standard imageThe SEM (figure 7(a)) and EDX-mapping (figure 7(b)) indicate the distribution of the element Ti, which comes from the nTiO2, in the functionalized nTiO2/polyurethane composite coatings prepared by the 'grafting from' method. Excellent distribution of the Ti in the nanocomposite coating was achieved by this technique, while large agglomeration and poor distribution of the Ti were achieved in conventional nTiO2/polyurethane coatings, as shown in figures 7(c) and (d). In the previously reported literature, larger aggregates of nTiO2 particles were observed in nTiO2/polyurethane nanocomposite films even after surface modification of the nTiO2 particles due to the high surface area, strong hydrogen bonding and high surface free energy [18]. Hence, this 'grafting from' polymerization method helped to provide excellent dispersion of the nTiO2 in the polymer matrix, which would enhance the overall properties of the composite coatings.
Figure 7. SEM and EDX-mapping of (a), (b) functionalized nTiO2/polyurethane composite coatings prepared by our novel 'grafting from' method and (c), (d) nTiO2/polyurethane coatings prepared by a conventional physical mixture method under the same magnification.
Download figure:
Standard image3.3. Antibacterial activity
The measurement of the bactericidal activities of the nTiO2/polyurethane nanocomposite films was conducted against gram-negative bacteria E. coli under solar illumination (AM 1.5G) on the basis of the decrease in the number of colonies of E. coli formed on an agar plate. When the films were irradiated under solar illumination, almost all of the bacteria were killed (>99.5%) in less than 1 h due to the photocatalytic effect of the nTiO2/polyurethane nanocomposite films, as shown in figure 8. The nTiO2/polyurethane composite generated OH⋅ radicals due to the photocatalytic property of the nTiO2 and the OH⋅ radicals damaged the bacterial cells due to a decrease in the Coenzyme A (CoA) content of the cell, which is a mediator of electron transport between the cell and nTiO2 [35, 36]. Neither pure polyurethane film nor nTiO2/polyurethane nanocomposite film in the dark showed any bacterial effects on E. coli. Moreover, a control experiment was conducted with pure polyurethane film to determine whether the E. coli cells could survive under solar illumination alone for 50 min. However, the results indicated only a slight decrease (∼9%) in the surviving bacteria colonies. According to figure 9 (inset), the photo-killing process of E. coli follows a pseudo-first-order kinetics with a rate constant k = 0.099 min−1. Similar pseudo-first-order kinetics for E. coli in artificial UV light have also been reported by other researchers [37, 38].
Figure 8. Images of E. coli colonies on an agar plate before and after solar illumination.
Download figure:
Standard imageFigure 9. Images of E. coli colonies on an agar plate before and after solar illumination. Inset: derivation of the pseudo-first-order rate constant k for E. coli by the nTiO2–PU nanocomposite film under solar illumination.
Download figure:
Standard image3.4. Self-cleaning activity
The photocatalytic self-cleaning properties of nTiO2/polyurethane nanocomposite films whave been investigated by monitoring the degradation of 'organic dirt' using FTIR spectroscopy in several investigations [39, 40]. The characteristic vibration bands of C–H bonds at 2923, 2853 (νas and νs stretching modes of the CH2 group respectively) and 2957 cm−1 (asymmetric stretching mode of the CH3 group) of stearic acid were examined in the FTIR spectra of the samples. This method worked well on the solid TiO2 film with no other obvious functional groups attached to the TiO2. However, the nTiO2/polyurethane films have characteristic vibration bands of C–H stretching at almost the same locations, therefore, the conventional way of spin coating the stearic acid solution as the organic film on the surfaces of the nTiO2/polyurethane coated substrates would no longer work. Hence, stearic acid was deposited on a transparent glass slide by spin coating from an 8 g l−1 stearic acid solution in tetrahydrofuran (THF) at 2000 rpm for 2 min. Then the side of the glass slide containing the stearic acid was kept in close contact with the surface of the nTiO2/polyurethane film under solar irradiation for different durations of time. The FTIR spectra of the stearic acid before and after solar irradiation were then recorded.
The FTIR spectra of the stearic acid film on the nTiO2/polyurethane composite coating are shown in figure 10. It is evident that the OH stretch peak of the FTIR spectra located at 3000–3600 cm−1 decreases upon UV irradiation with time and a complete degradation of the stearic acid was observed by the disappearance of the OH peaks when exposed to UV light irradiation for 24 h. According to the photocatalytic degradation mechanism, the stearic acid first degrades into acetic acid, which then oxidizes into carbon dioxide [11]. Throughout every step, both H2O and CO2 are the compound gases which are generated by the photocatalytic oxidative reaction. Therefore the removal of stearic acid with UV light irradiation indicates that the nTiO2/polyurethane composite coatings have good self-cleaning properties.
Figure 10. The FTIR absorbance spectra to monitor the degradation of stearic acid before and after solar irradiation.
Download figure:
Standard image4. Conclusion
Novel nTiO2/polyurethane composite coatings were synthesized by coordinating nTiO2 to the backbone of polyurethane polymer matrix by the 'grafting from' polymerization method. This coordination was achieved by the functionalization of nTiO2 with DMPA. The optimum molar ratio between the DMPA and the nTiO2 in monomer functionalization was obtained as 2.4 at a reaction temperature of 80 °C. As per SEM and EDX-mapping the elemental Ti dispersed homogeneously in the polymer matrix without any significant agglomeration compared to the conventional physical mixture of nTiO2 in polyurethane coating. The functionalized nTiO2/polyurethane composite coatings showed outstanding antibacterial properties towards gram-negative bacteria E. coli under solar irradiation. Almost all of the bacteria (>99.5%) were eliminated within 50 min due to the photocatalytic effect of the nTiO2 in the polyurethane coatings.
Acknowledgments
The authors would like to thank Dr Todd Simpson for the SEM/EDX analysis. This work was financially supported by the Canadian Natural Science and Engineering Research Council (NSERC).